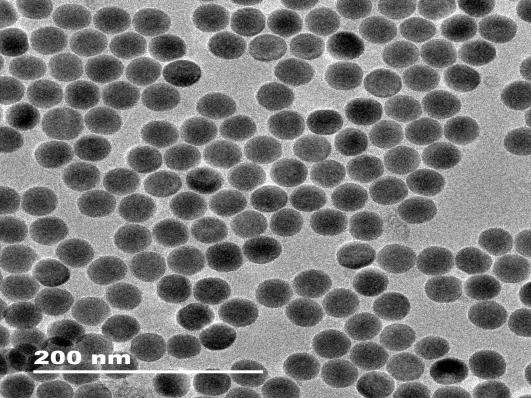
SH-PEG1000-core-shell upconversion Nanoparticles,ex980nm,20-30nm

Home > products > luminescent-nanoparticles
> upconversion-luminescent-material
> sh-peg1000-core-shell-upconversion-nanoparticles-ex980nm-20-30nm
SH-PEG1000-core-shell upconversion Nanoparticles,ex980nm,20-30nm
 NaYF4:Yb,Er@NaYF4(SH-PEG1000 modified core-shell ucnps,980 excitation)
NaYF4:Yb,Er@NaYF4(SH-PEG1000 modified core-shell ucnps,980 excitation)
| Catalog # | Pkg Size | Price(USD) | Quantity | Buy this product |
|---|---|---|---|---|
| R-M2-9431 | 5ml | 859.00 | + Add to cart |
|
| R-M2-9431 | 10ml | 1508.00 | + Add to cart |
|
|
|
||||
Product description
SH-PEG1000-core-shell upconversion nanoparticles/NaYF4:Yb,Er@NaYF4(SH-PEG1000 modified core-shell ucnps,980 excitation) represent a versatile and promising material.SH-PEG1000-core-shell UCNPs can be used in in vivo imaging due to their NIR excitation and visible emission, which minimizes tissue scattering and absorption.They can serve as carriers for drug molecules, with the PEG layer facilitating biocompatibility and circulation within the bloodstream.UCNPs can generate reactive oxygen species (ROS) upon NIR irradiation, providing a modality for targeted cancer therapy.The photostability of UCNPs allows for their use in biosensors with improved sensitivity and detection limits.
| Appearance | Liquid |
|---|---|
| Concentration | 2mg/ml |
| Solubility | Water |
| Excitation wavelength | 980nm |
| Emission wavelength | 540 / 650nm ±2nm |
| Size | 20-30nm |
| Storage | 4℃, protected from light and moisture |
| Transportation | 4-25℃ temperature for up to 3 weeks |
| Stability | 6 months |
Document
Related Product

 Items-$0.00
Items-$0.00

 Email:
Email: Tel.:
Tel.: msds of NaYF4 Yb,Er@NaYF4(SH-PEG1000 modified core-shell ucnps,980 excitation)
msds of NaYF4 Yb,Er@NaYF4(SH-PEG1000 modified core-shell ucnps,980 excitation)  RuixiBiotechCo.Ltd /KamulinBiotechco.ltd
RuixiBiotechCo.Ltd /KamulinBiotechco.ltd
 Add: Room 20F 2002, Meiyuan Building, Yanta District, Xi’ an City, Shaanxi Province 710061 China
Add: Room 20F 2002, Meiyuan Building, Yanta District, Xi’ an City, Shaanxi Province 710061 China
 Tel: 02988811435
Tel: 02988811435
 Fax: (86-29)8881-1435
Fax: (86-29)8881-1435
 Email: sales@ruixibiotech.com
Email: sales@ruixibiotech.com
 Web: http://www.ruixibiotech.com
Web: http://www.ruixibiotech.com


